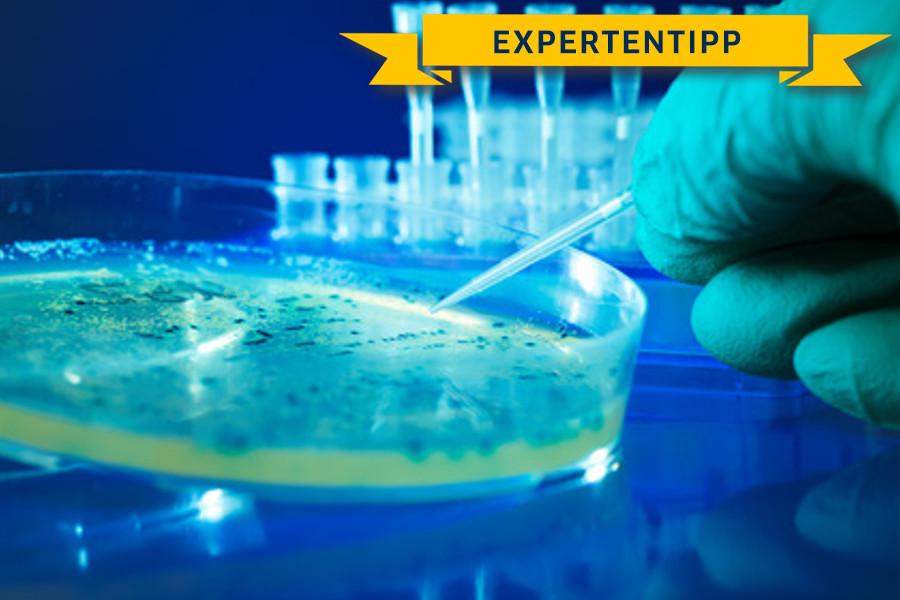
Pseudomonas aeruginosa im Leitungswasser

Pseudomonas aeruginosa im Leitungswasser
Pseudomonas aeruginosa sind Bakterien, die im Wasser
vorkommen können und u.a. zu Infektionen der Haut führen können. Durch
deren hohe Antibiotikaresistenz/Desinfektionsmittelresistenz und der
Relevanz in Krankenhäusern sind die Bakterien auch als „Krankenhauskeim“
bekannt. In Hochrisikobereichen gehört die regelmäßige Wasseranalyse
auf Pseudomonas aeruginosa bereits in den Pflichtkatalog dazu.
Die
Ursachen für Pseudomonas aeruginosa im Trinkwasser sind vielfältig. Den
Keim findet man zunächst auch in Oberflächengewässern. Treten also
auffällige Werte von Pseudomonas auch im Leitungswasser auf, liegt der
Verdacht nahe, dass ein Einfluss durch Oberflächenwasser besteht. Dies
kann z.B. dann sein, wenn das Trinkwasser oberflächennah gewonnen wird
oder die Wasserdurchlässigkeit der Bodenschichten über dem
Grundwasserleiter sehr hoch ist. Problematisch kann der Keim auch in
wärmeren Ländern sein. Dort ist er oftmals Ursache für Ohrenentzündungen
(z.B. unzureichend gechlortes Poolwasser).
Jedoch kann Pseudomonas
aeruginosa auch ganze Wassersysteme befallen. Dies kann durch
Bauarbeiten an den Rohrleitungen, durch die Einspeisung oder durch die
Installation technischer Geräte erfolgen. So sind in Deutschland Fälle
bekannt, dass durch neu eingebaute Wasserzähler die Bakterien ins
Trinkwasser gelangt sind.
Für gesunde Personen stellen die Bakterien in der Regel keine Gefahr dar. Bei Personen, die medizinischer Pflege oder Behandlung bedürfen, ist das gesundheitliche Risiko weitaus höher. Pseudomonas aeruginosa können hier im Wasser bei Kontakt mit Hautverletzungen zu Hautinfektionen führen. Daher sind vor allem Patienten nach einer OP betroffen, die sich durch belastetes Trinkwasser eine sogenannte Krankenhausinfektion zuziehen. Die Wasseranalyse auf Pseudomonas ist daher in Krankenhäusern oder auch Zahnarztpraxen längst Bestandteil von Hygieneplänen. Das Trinkwasser muss in jedem Fall frei von krankheitserregenden Keimen sein. Diese Anforderung wird nicht nur an das Leitungswasser in Kliniken gestellt, sondern auch an jedes Wohnhaus.
Bei Verdacht auf eine beeinträchtigte Wasserqualität ist der erste
Schritt die genaue Wasseranalyse. Der Verdacht kann somit bestätigt oder
widerlegt werden. Mehrere Wasseruntersuchungen in regelmäßigen
Abständen liefern dann nicht nur Momentaufnahmen, sondern geben noch
genauer den Status der Wasserqualität wieder. Sind Pseudomonas aeruginosa in den Analysen mehrfach gefunden worden, sind weitergehende Maßnahmen
notwendig. Je nach System können dies Spülungen, Desinfektionsverfahren
(auch in Kombination) und Materialaustausch sein. Endverbraucher können
sich meist bereits mit einer kleinen Maßnahme vor Schadstoffe schützen:
Lassen Sie das Stagnationswasser ablaufen. D.h. drehen Sie Ihr
Kaltwasser auf und warten Sie bis frisches, kaltes Wasser aus dem Hahn
fließt. Sie haben nämlich dann das gesamte Stagnationswasser ausgespült
(also das Wasser, welches über mehrere Stunden in den Leitungen steht
und dadurch wahrscheinlicher belastet ist).
Außerdem empfiehlt es sich, einen Biofilm an der Innenseite der Rohre zu vermeiden, da sich Pseudonomas aeruginosa dort ansiedeln und vermehren. Wie Sie den Biofilm entfernen können lesen sie in unserem Beitrag "Biofilm entfernen".
BDEW, DVGW, VDDW: Auftreten von Pseudomonas aeruginosa in Wasserzählern
WAZ: Zeitungsartikel zu Pseudomonas aeruginosa & Wasserzähler
Checknatura: Pseudomonas Aeruginosa im Trinkwasser
Komplett-Wassertest chemisch + mikrobiologisch
✔️
Test-Wasser.de-Empfehlung
✔️
Chemische Parameter
✔️
Mikrobiologische Parameter
Wassertest mikrobiologisch
✔️
hygienerelevante Parameter
✔️
E. coli, coliforme Keime
✔️
zwei Gesamtkeimzahlen
Wassertest auf Legionellen
✔️
gezielte Untersuchung
✔️ leichte Durchführung
✔️
Legionellen sicher identifizieren
Komplett-Wassertest Plus chemisch + mikrobiologisch + Legionellen
✔️
Komplett-Test mit Legionellen
✔️
Chemische Parameter
✔️
Mikrobiologische Parameter









